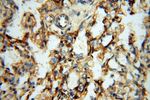
ERG Antibody in Immunohistochemistry (Paraffin) (IHC (P))

Search
Proteintech
ERG Polyclonal Antibody
{{$productOrderCtrl.translations['antibody.pdp.commerceCard.promotion.promotions']}}
{{$productOrderCtrl.translations['antibody.pdp.commerceCard.promotion.viewpromo']}}
{{$productOrderCtrl.translations['antibody.pdp.commerceCard.promotion.promocode']}}: {{promo.promoCode}} {{promo.promoTitle}} {{promo.promoDescription}}. {{$productOrderCtrl.translations['antibody.pdp.commerceCard.promotion.learnmore']}}
产品信息
14356-1-AP
种属反应
已发表种属
宿主/亚型
分类
类型
抗原
偶联物
形式
浓度
规格
纯化类型
保存液
内含物
保存条件
运输条件
产品详细信息
Immunogen sequence: RQWLEWAVK EYGLPDVNIL LFQNIDGKEL CKMTKDDFQR LTPSYNADIL LSHLHYLRET PLPHLTSDDV DKALQNSPRL MHARNTGGAA FIFPNTSVYP EATQRITTRP DLPYEPPRRS AWTGHGHPTP QSKAAQPSPS TVPKTEDQRP QLDPYQILGP TSSRLANPGS GQIQLWQFLL ELLSDSSNSS CITWEGTNGE FKMTDPDEVA RRWGERKSKP NMNYDKLSRA LRYYYDKNIM TKVHGKRYAY KFDFHGIAQA LQPHPPESSL YKYPSDLPYM GSYHAHPQKM NFVAPHPPAL PVTSSSFFAA PNPYWNSPTG GIYPNTRLPT SHMPSHLGTY Y (140-479 aa encoded by BC040168)
靶标信息
v-ets erythroblastosis virus E26 oncogene like isoform 2 (ERG) is a transcriptional regulator. It may participate in transcriptional regulation through the recruitment of SETDB1 histone methyltransferase and subsequent modification of local chromatin structure.
仅用于科研。不用于诊断过程。未经明确授权不得转售。
生物信息学
蛋白别名: avian erythroblastosis virus E-26 (v-ets) oncogene related; ERG, ETS transcription factor; ERG/EWS fusion gene; ERG/FUS fusion gene; ERG/TMPSSR2 fusion gene; ERG1; erg1 protein; ets-related; FUS/ERG fusion protein; H Kv11.3; HGNC:3446; KCNH2; Oncogene ERG; OTTHUMP00000115970; OTTHUMP00000208036; TMPRSS2/ERG fusion; transcription factor; ERG7; transcription factor; ERG8; transcriptional activator; Transcriptional regulator ERG; transcriptional regulator ERG (transforming protein ERG); Transforming protein ERG; unnamed protein product; v-ets avian erythroblastosis virus E26 oncogene homolog; v-ets avian erythroblastosis virus E26 oncogene related; v-ets erythroblastosis virus E26 oncogene homolog; v-ets erythroblastosis virus E26 oncogene like
基因别名: D030036I24Rik; ERG; Erg-3; LMPHM14; p55
UniProt ID: (Human) P11308, (Mouse) P81270
Entrez Gene ID: (Human) 2078, (Rat) 170909, (Mouse) 13876